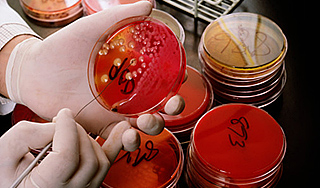
В Сибири повар заразился опасной инфекцией В Сибири повар заразился опасной инфекцией

10 октября, четверг | ![]() ![]() ![]() |
![]() | ПОЛИТИКА | ЭКОНОМИКА | ОБЩЕСТВО | ПРОИСШЕСТВИЯ | КУЛЬТУРА | СПОРТ | МЕДИА | В МИРЕ | АВТО | ТЕХНОЛОГИИ | ![]() |
| Фоторепортажи | Видеосюжеты | Комментарии | Погода | Работа | Форум | Карта | Подписка и RSS | Реклама| О газете |
В Сибири повар заразился опасной инфекцией28 октября 2011, пятница, 10:24 – БРЯНСК.RU | Комментарии: 0
| Версия для печати У жительницы Новосибирской области нашли сибирскую язву. Началось эпидемиологическое расследование, результаты которого будут сообщены через десять дней. По некоторым данным, заболевшая работала поваром в кафе.Инцидент произошел в Чановском районе Новосибирской области. Женщина попала в больницу с подозрением на заболевание сибирской язвой. "Женщина госпитализирована в инфекционный стационар Новосибирска, она в удовлетворительном состоянии. Анализы будут в течение десяти дней", – приводит слова заместителя руководителя управления Роспотребнадзора по Новосибирской области Бориса Ягудина РИА Новости. Распространившуюся информацию о том, что заболевшая работает поваром в заведении общественного питания, чиновник комментировать отказался. Сибирская язва - это острое инфекционное заболевание, протекающее с лихорадкой, поражением лимфатического аппарата и интоксикацией. Источником инфекции могут стать домашние животные: коровы, овцы, козы, верблюды, свиньи. Заражение человека чаще осуществляется контактным путем, например, при разделке туш животных или обработке шкур, а также при употреблении в пищу продуктов, загрязненных спорами. Кроме того, возможно инфицирование через воду, почву, меховые изделия. Заражения от человека к человеку обычно не происходит. Как писали Дни.Ру, в июле 2011 года от сибирской язвы скончался 64-летний житель Грузии, проживавший в Тетрицкаройском районе. Мужчина заразился спорами бактерии во время разделки павшей коровы у себя дома. В больницу он обратился только спустя шесть дней и, несмотря на усилия медиков, умер от почечной и легочной недостаточности. Источник:
|
![]() | ПОЛИТИКА | ЭКОНОМИКА | ОБЩЕСТВО | ПРОИСШЕСТВИЯ | КУЛЬТУРА | СПОРТ | МЕДИА | В МИРЕ | АВТО | ТЕХНОЛОГИИ | ![]() |
| Фоторепортажи | Видеосюжеты | Комментарии | Погода | Работа | Форум | Карта | Подписка и RSS | Реклама| О газете |
| Размещение рекламы в газете БРЯНСК.RU: Прайс-лист, тел. (4832) 37-19-38, почта info@briansk.ru Для информационных писем в редакцию: news@briansk.ru | ![]() | ![]() | ||
| 2005–2015 © Ежедневная интернет-газета БРЯНСК.RU При цитировании активная ссылка на БРЯНСК.RU обязательна Материалы газеты могут содержать информацию 18+ | ![]() | Открыв данный сайт, Вы соглашаетесь с Правилами cайта (договор-оферта). Если вы не согласны с Правилами, немедленно покиньте сайт! | ![]() |

В глубине экрана: Мастер-класс по ремонту телевизоров
Погружение в мир футбола онлайн: для поклонников Игры
Займ без проверок
Тотализаторы: что это такое и чем они отличаются от обычных ставок?
Играть в бесплатные игровые автоматы в онлайн-клубе Вулкан
Стоит ли посещать офтальмолога при замене очков?
Успешные игроки предпочитают игровые автоматы Вулкан
Новое казино Супер Слотс поможет воплотить ваши мечты в реальность







ПОПУЛЯРНЫЕ МАТЕРИАЛЫ










